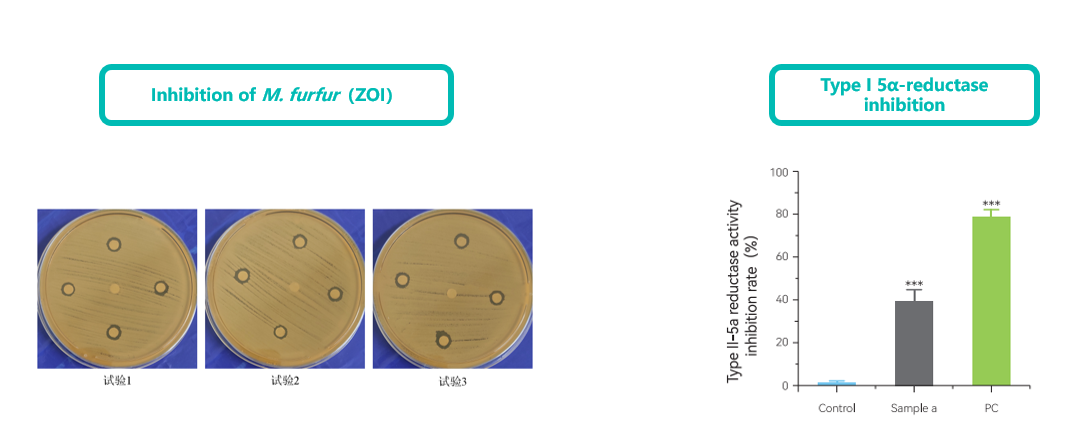

Efficacy | Evaluation Model | Evaluation Indicator |
Anti-peeling/ Anti-dandruff/ Scalp care | Inhibition of Malassezia | Bacterial growth inhibition zone, MIC |
Type II 5α- reductase inhibition experiment | Inhibition rate of dihydrotestosterone (DHT) generation | |
Testing of cell proliferation, migration rate, and aggregation ability in DPC (dermal papilla cells) | Cell proliferation, migration rate, and aggregation ability | |
Induction of DPC (dermal papilla cells) injury model by dihydrotestosterone (DHT) | Expression of growth factors (VEGF, IGF, FGF, etc.) and AR | |
Induction of DPC (dermal papilla cells) injury model by hydrogen peroxide | Expression of growth factors (VEGF, IGF, FGF, etc.) , measurement of ROS content | |
Isolated hair follicles of mice | Tissue viability | |
Inhibition of LNCaP cell proliferation | Cell vitality | |
Stimulation of sebum secretion in sebaceous gland cells by dihydrotestosterone (DHT) | Lipid droplets, Expression of genes related to lipid synthesis (SREBP-1, FAS) |
